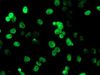

PADI4 Mouse Monoclonal Antibody [Clone ID: OTI4H5]
CAT#: CF504813
Carrier-free (BSA/glycerol-free) PADI4 mouse monoclonal antibody, clone OTI4H5 (formerly 4H5)
Formulation: Standard
Specifications
| Product Data | |
| Clone Name | OTI4H5 |
| Applications | FC, IF, IHC, WB |
| Recommended Dilution | WB 1:2000, IHC 1:150, IF 1:100, FLOW 1:100 |
| Reactivities | Human, Mouse, Rat |
| Host | Mouse |
| Isotype | IgG2a |
| Clonality | Monoclonal |
| Immunogen | Full length human recombinant protein of human PADI4(NP_036519) produced in HEK293T cell. |
| Formulation | Lyophilized powder (original buffer 1X PBS, pH 7.3, 8% trehalose) |
| Reconstitution Method | For reconstitution, we recommend adding 100uL distilled water to a final antibody concentration of about 1 mg/mL. To use this carrier-free antibody for conjugation experiment, we strongly recommend performing another round of desalting process. (OriGene recommends Zeba Spin Desalting Columns, 7KMWCO from Thermo Scientific) |
| Purification | Purified from mouse ascites fluids or tissue culture supernatant by affinity chromatography (protein A/G) |
| Conjugation | Unconjugated |
| Storage | Store at -20°C as received. |
| Stability | Stable for 12 months from date of receipt. |
| Predicted Protein Size | 73.9 kDa |
| Gene Name | peptidyl arginine deiminase 4 |
| Database Link | |
| Background | This gene is a member of a gene family which encodes enzymes responsible for the conversion of arginine residues to citrulline residues. This gene may play a role in granulocyte and macrophage development leading to inflammation and immune response. [provided by RefSeq] |
| Synonyms | PAD; PAD4; PADI5; PDI4; PDI5 |
| Reference Data | |
Documents
| Product Manuals |
| FAQs |
| SDS |
Resources
| Antibody Resources |
Other Versions
| SKU | Description | Size | Price |
|---|---|---|---|
| TA504813 | PADI4 mouse monoclonal antibody, clone OTI4H5 (formerly 4H5) |
USD 447.00 |
|
| TA504813S | PADI4 mouse monoclonal antibody, clone OTI4H5 (formerly 4H5) |
USD 159.00 |
|
| TA600440 | PADI4 Capture mouse monoclonal antibody, Luminex validated, clone OTI4H5 |
USD 379.00 |
|
| TA700441 | PADI4 biotinylated detection antibody, Luminex validated mouse monoclonal antibody, clone OTI4H5 |
USD 399.00 |
{0} Product Review(s)
Be the first one to submit a review






























































































































































































































































 Germany
Germany
 Japan
Japan
 United Kingdom
United Kingdom
 China
China